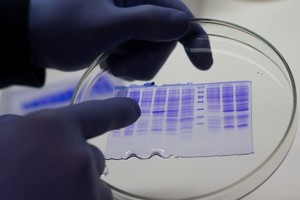

"La molécula molnupiravir en investigación de Fase 3 consiste en un potencial medicamento antivírico oral que podría prevenir la replicación de virus de ARN, incluidos SARS-CoV-2", describió el laboratorio norteamericano MSD (Merck Sharp & Dohme), responsable de las investigaciones en colaboración con Ridgeback Biotherapeutics, en un comunicado.
Coronavirus: Argentina participará de un ensayo de tratamiento antiviral
Argentina se sumará al ensayo clínico de molnupiravir, un potencial antiviral de administración oral para el tratamiento inicial de la infección por coronavirus, informó hoy el laboratorio que llevará adelante el estudio cuyos resultados se esperan para octubre de 2021.

El estudio, denominado MOVe-OUT, se lleva a cabo simultáneamente en varios países como Brasil, Chile, Colombia, Francia, Guatemala, Bulgaria, Alemania, Israel, Italia, Japón, Egipto, Filipinas, Polonia, Rusia, Canadá y Estados Unidos.
En Argentina, se realizará en la Clínica Independencia, en el partido bonaerense de Vicente López, y en el Instituto Médico de la Fundación Estudios Clínicos de Rosario, en Santa Fe.

Según detalló el comunicado, el estudio evaluará el molnupiravir durante cinco días.
"La dosificación y forma de administración se determinó en la fase previa de investigación del fármaco, finalizada en marzo de este año, y que evidenció la actividad antiviral del molnupiravir en pacientes que no fueron hospitalizados con Covid-19 confirmado y síntomas iniciales", indicó el comunicado.
En la etapa actual de la investigación, se evaluará la seguridad y eficacia del medicamento.

Los requisitos para participar son tener al menos 18 años, haber dado positivo en Covid-19 en los últimos 4 días, tener al menos un síntoma de Covid-19, como fiebre, tos o pérdida del gusto u olfato, no estar hospitalizado y no haber recibido la vacuna, entre otros.
Los interesados pueden contactarse con [email protected] o [email protected].
Con información de Télam